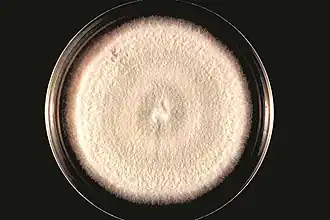

Acremonium strictum
| Acremonium strictum | ||||||||||||
|---|---|---|---|---|---|---|---|---|---|---|---|---|
Kultur von Acremonium falciforme | ||||||||||||
| Systematik | ||||||||||||
| ||||||||||||
| Wissenschaftlicher Name | ||||||||||||
| Acremonium strictum | ||||||||||||
| W.Gams (1971) |
Acremonium strictum ist ein Pilz aus der Familie der Bionectriaceaen. Die saprotrophe Art wird bei unterschiedlichen Umweltbedingungen in Böden und abgestorbenen Pflanzen- und Pizresten gefunden.[1] Isolate der Art wurden in Nord- und Mittelamerika, Asien, Europa und Ägypten gesammelt.[2] A. strictum ist ein Verursacher einer Hyalohyphomycose und wurde als zunehmend häufiges Pathogen bei Patienten mit unterdrückten Immunfunktionen identifiziert, das lokale, verstreute und invasive Infektionen verursacht.[2][3][4] Obwohl dies extrem selten vorkommt, kann A. strictum auch Individuen mit intaktem Immunsystem und Neugeborene befallen.[3][4] Wegen der wachsenden Zahl der Infektionen, die von A. strictum in den letzten paar Jahren ausgelöst wurden, hat der Bedarf an neuen medizinischen Techniken zur Identifikation und auch an Behandlungsmöglichkeiten beträchtlich zugenommen.[5]
Es gibt Nachweise über das Einbezogensein von A. strictum in einige mykoparasitische Beziehungen; darüber hinaus ist auch ein weites Spektrum endophytischer und parasitischer Beziehungen zu anderen Organismen nachgewiesen;[6][7][8][9] weitergehende Untersuchungen sind erforderlich, die Nutzung von A. strictum als Reagens zur biologischen Schädlingsbekämpfung und seine Rolle bei der Ertragsminderung zu ermitteln. A. strictum bezieht viele Produkte in den Stoffwechsel ein, was seine künftige Bedeutung in der Landwirtschaft und in der Pharmazie nahelegt.[10][11]
Beschreibung
Acremonium ist eine große polyphyletische Gattung mit etwa 150 Arten, von denen viele aus eng verwandten Familien der Klasse Sordariomycetes abgeleitet sind.[12] Die Gattung enthält viele langsam wachsende, einfach strukturierte, anamorphe filamentöse Pilze,[3][5][12] die typischerweise in feuchten, Zellulose-basierten Materialien unter ständig feuchte Bedingungen angetroffen werden. Charakteristisch für die morphologischen Merkmale dieser Gattung sind Hyphen mit einem Septum, die dünne zugespitzte Phialiden, welche wiederum einzellig sind, oder schwach verzweigte Konidiophoren ausbilden.[1][5][12] Infektionen bei Menschen kommen, obwohl sie selten sind, bei Personen mit ernsthaft geschwächtem Immunsystem vor.[2] A. strictum wird meist in mykoparasitischen Beziehungen sowie als Pflanzenparasit und Endophyt angetroffen.[6][13][14]
Morphologische Identifikation
Aussehen der Kolonien
Acremonium strictum wächst rasch bei 30 °C auf Glukose-Pepton-Agar, wobei das Myzel innerhalb von sieben Tagen maximal um 50 mm wächst. Die Kolonien sind flach, mit weicher, feuchter, samtartiger oder flockiger Textur, die manchmal baumwollenen Buckeln ähneln.[15] Die Farbe der Myzelien reicht von hellrosa bis orange; manchmal sind sie gelb, weiß oder grün.[5][15] Die Filamente von A. strictum sind manchmal zu stärkeren Strukturen von mehreren Zellschichten verbunden.[1] Die Konidien wachsen als feuchte Klumpen oder trockene Ketten,[1] und die erzeugten körnigen Strukturen sind weiß bis blassgelb, weich und von variabler Gestalt.[1] Subkulturen des Pilzes können gleichfalls innerhalb von sieben Tagen heranwachsen; die weichen, feuchten, rosa Myzelien ähneln dünner Baumwolle.[5][16]
Mikroskopische Erscheinung

Unter dem Mikroskop zeigt A. strictum bei 30 °C lange, schlanke Phialiden. Die Conidien sind zylindrisch oder ellipsoidal und zu schleimigen Bündeln an den Spitzen der Phialiden geformt. Bei geringer Vergrößerung zeigen sich stecknadelkopfförmige Sporenball-Bildungen.[15]
Die Arten der Gattung Acremonium sind sich morphologisch sehr ähnlich, was die Identifikation erschwert. Im Bild ist die mikroskopische Aufnahme von A. falciforme zu sehen, das die morphologischen Ähnlichkeiten zur A. strictum zeigt. Oft werden mehrere verschiedene Acremonium-Arten einfach als Acremonium bezeichnet, was die Häufigkeit akkurater Informationen über das klinische Auftreten von A. strictum verringert.[5] Isolate phylogenetisch entfernt verwandter Acremonium-Arten zeigen erhebliche Analogien.[12] Da es sich auch um ein Pathogen des Menschen handelt, wird die Diagnose durch Isolate gestellt, d. h. die Bestimmung des Pilzes wird durch Körnchen im Gewebe sowie aus der Anwesenheit der Hyphen bei mikroskopischer Begutachtung von Biopsien und Ausflüssen vorgenommen.[1][3]
Morphologisch zu Acremonium ähnliche Gattungen sind u. a. Fusarium, Phaeoacremonium, Verticillium, Phialemonium und Lecanicillium.[5]
Genetische Identifikation
Die Identifikation von Isolaten von A. strictum hat gezeigt, dass der Pilz phänotypisch divers auftritt und genetisch variieren kann.[16] Aufgrund der phylogenetischen Uneindeutigkeit beruht ein unbekannter Anteil der über A. strictum verfassten Literatur auf Untersuchungen von Acremonium sclerotigenum.[12] Der Pilz kann im Allgemeinen durch nukleare ITS-Region-Sequenzanalyse bestimmt werden.[5][17] Die Analysen der großen ribosomalen Untereinheit (englisch ribosomal large subunit, LSU) und der gesamten kleinen Untereinheit (englisch small subunit, SSU) hilft auch, die phylogenetischen Beziehungen aufzuklären, da diese Gene stärker konserviert und somit weniger Gegenstand evolutionärer Veränderungen sind.[12] Die Art A. strictum wird in drei genetische Gruppen untergliedert. Gengruppe I wird durch den Typ des Stammes CBS 346.70 repräsentiert, Gengruppe II durch UW836 und Gengruppe III durch UWFP940. Diese Gengruppen wurden auf der Basis von GenBank-Daten zu A. strictum gebildet.
Taxonomie
Folgende Synonyme sind bekannt:
- Cephalosporium acremonium Corda (1839)[18]
- Cephalosporium acremonium var. majus Penz. (1882)[18]
- Cephalosporium acremonium var. uniseptatum Massee ex Sacc. (1892)[18]
- Cephalosporium acremonium var. natricis Frágner (1958)[18]
- Cephalosporium majus (Penz.) Mussat (1901)[18]
- Haplotrichum acremonium (Corda) Pound & Clem. (1896)[18]
- Hyalopus acremonium (Corda) M.A.J.Barbosa (1941)[18]
- Sarocladium strictum (Gams) Summerbell (2011)[19]
- Tilachlidium medietatis Novobr. (1972)[18][19]
Infektionen beim Menschen
Pathophysiologie
Infektionen durch Acremonium strictum bei Menschen sind sehr selten und entwickeln sich normalerweise nach einer traumatischen Inokulation des Pilzes.[5] Eine Hyalohyphomycose kann bei Personen mit geschwächtem Immunsystem auftreten und durch hyaline oder farblose Hyphen im infizierten Gewebe erkannt werden.[1][4] Es wurden auch Peritonitis und Pleuritis als Resultat von Infektionen mit A. strictum beschrieben,[20][21] aber von Infektionen der Haut oder Unterhaut wird nur selten berichtet.
- Die meisten Infektionen beim Menschen wurden bei Personen mit Immundefekten beobachtet und als lokale oder gestreute Infektionen des Blutes oder des Auges oder als Myzetom beschrieben,[2][4] was oft als schwerer Fall endet.[3] A. strictum kann invasive Infektionen wie Pneumonie, Arthritis, Osteomyelitis, Endokarditis, Meningitis oder Sepsis bei Patienten mit geschwächtem Immunsystem hervorrufen.[3][20]
- Infektionen bei immunkompetenten Personen folgen normalerweise auf eine Inokulation während der Verletzung der Extremitäten oder der Hornhaut und enden in lokalen Infektionen.[3] Der Pilz kann außerdem Nagelpilz, eine Ontomykose (Infektion eines oder beider Ohren) oder eine Infektion von Verbrennungswunden auslösen.[3] Patienten mit Herzklappen-Prothesen, die in der Region der Klappen mit A. strictum infiziert wurden, können von schwerwiegenden Entzündungen betroffen sein, die in Sepsis oder multiplem Organversagen enden.[17]
- Infektionen können – wenn auch selten – bei Neugeborenen auftreten und dann schwerwiegende Folgen haben.[4]
Viele Umweltfaktoren wie die Häufigkeit der Pilze im Boden, Niederschläge, Temperatur, Feuchtigkeit und Vegetationstyp beeinflussen in engem Kontakt die Wahrscheinlichkeit einer Hyalohyphomycose-Infektion durch A. strictum.[3] Der häufige Kontakt mit kontaminiertem Wasser in Verbindung mit hohen Temperaturen und Feuchtigkeit erhöht das Risiko einer Infektion.[3]
Klinische Erscheinung und Behandlung
Die klinische Erscheinung einer Infektion ist ungenau definiert, aber die meisten Patienten werden Hautausschläge und grippeähnliche Symptome wie erhöhte Temperatur und Erschöpfung aufweisen.[1][3] Bei schweren Infektionen wie bei immungeschwächten Patienten werden auch Peritonitis und Pleuritis, die schließlich zu multiplem Organversagen führen, auftreten.[20][21] Im Falle invasiver Infektionen kann ein chirurgischer Eingriff erforderlich sein, um die Pilze aus den Körpergeweben zu entfernen.[4] Aufgrund der beschränkten krankheits-definierten Fälle und der Varianzen der klinischen Erscheinung wie auch aufgrund der unsicheren Identifikation der Pilzart ist keine optimale Behandlung verfügbar.[2] A. strictum und andere Acremonium-Arten sind im Allgemeinen gegen die meisten Antimykotika resistent; dennoch wird ein Test der Empfindlichkeit gegen ein Antimykotikum empfohlen, um die angemessenste Behandlung für den jeweiligen Stamm von A. strictum, der die Infektion auslöste, zu ermitteln.[3] Eine Therapie mit Amphotericin B in Verbindung mit Ketoconazol wird normalerweise als beste verfügbare Behandlung empfohlen.[2][3]
Biologische Bekämpfung
Es wurde nachgewiesen, dass mit A. strictum infizierte Setzlinge eine hohe Mortalitätsrate aufweisen. Es wäre landwirtschaftlich bedeutsam, biologische Schädlingsbekämpfungsmittel für diesen Pilz zu finden. Die oberirdischen Teile von Kamelgras (Cymbopogon schoenanthus), Hyptis spicigera, des Wandelröschens (Lantana camara) und Ocimum americanum wurden gesammelt und über vier Tage getrocknet. Nach dem Trocknen wurden essentielle Öle extrahiert. Eine Reihe von Samen wurden mit Pilzen, darunter auch Kohorten von A. strictum, inokuliert. Die Öle wurden auf die infizierten Samen aufgebracht. Nach dem Keimen der Samen wurde ein signifikant gehemmtes Wachstum der Myzelien von A. strictum beobachtet.[22]
Interaktionen mit anderen Pilzen
Acremonium strictum ist allgemein als Pilzparasit bekannt, was sich auch in seiner antagonistischen Beziehung zum Silberschorf (Helminthosporium solani) zeigt. Der Silberschorf ist ein Pathogen der Kartoffel, der seit seinem ersten Auftreten in den Vereinigten Staaten extreme und weit verbreitete Verluste aller Marktklassen der Kartoffel auslöste. Der Pilz verursacht Makel, die die Qualität der Kulturen derart verringern, dass sie nicht mehr vermarktet werden können. In schwereren Fällen verursacht der Silberschorf einen Gewichtsverlust und Läsionen im Periderm, die anderen Pathogenen Zugang verschaffen. In Reinkultur zeigt der Silberschorf weiße Sektoren und Ringe, eine differenzierte Färbung und eine reduzierte Sporulation. Nach einer Infektion mit A. strictum werden diese Kulturen einheitlich schwarz ohne weiße Sektoren und Ringe. A. strictum war in der Lage, die Sporulation des Silberschorfs signifikant um 30 %, die Sporenkeimung um 20 % und das Myzel-Wachstum um 8 % zu verringern. Dies legt nahe, dass A. strictum als biologisches Schädlingsbekämpfungsmittel gegen den Silberschorf eingesetzt werden kann, was den Ertrag der Kartoffelkulturen stark erhöhen würde.[6]
Interaktionen mit Pflanzen
Stängelfäule
Acremonium strictum ist ein Pathogen für viele einkeimblättrige und zweikeimblättrige Kulturpflanzen, das ein Austrocknen der Blätter auf einer Seite der Mittelrippe, ein Welken und abnorme, entfärbte Leitgewebe des Stängels nahe der Basis verursacht. Die Leitgewebe bilden orange, rote und braune Bündel; die Pflanze stirbt schließlich ab. Die Infektion mit A. strictum ist systemisch, so dass der Pilz aus allen Pflanzengeweben isoliert werden kann. Die Isolate wurden auch in Samen gefunden, was möglicherweise den Startpunkt der Infektion darstellt. Zu den betroffenen Kulturen gehören Akazien, Erlen, Feigen, Bohnen, Baumwolle, Weizen und Mais. Wegen seiner ubiquitären Präsenz im Boden beeinflusst A. strictum viele landwirtschaftlich genutzte Arten negativ, obwohl noch einige Forschung nötig ist, um die parasitischen Interaktionen aufzuklären und Strategien für eine biologische Schädlingsbekämpfung zu entwickeln.[13]
Wurzelgallenälchen
Das Südliche Wurzelgallenälchen (Meloidogyne incognita) ist ein polyphager Fadenwurm (Nematoda), der Tomatenpflanzen ernsthaft schädigen kann, indem er Läsionen an den Wurzeln durch Einsatz eines Stiletts hervorruft, was bodenlebenden pilzlichen Parasiten das Eindringen in den Wirt ermöglicht und komplexe Krankheitsbilder auslösen kann. A. strictum wird als Ei-Parasit des Südlichen Wurzelgallenälchens beschrieben, weil die Eier des Fadenwurms in infizierten Pflanzen nach einer Behandlung mit A. strictum leer vorgefunden wurden. Die Anwendung von A. strictum gemeinsam mit Trichoderma harzianum erwies sich bei Tomatenpflanzen als aussichtsreiche Methode der Bekämpfung des Wurzelgallenälchens.[14]
Erdbeeren
A. strictum zeigt eine komplizierte Beziehung zu Gartenerdbeeren (Fragaria × ananassa),[7] in welchen der Pilz Läsionen und kleine nekrotische hellbraune Flecken auf den Blättern und Blattstielen verursachen kann, die sich mit fortschreitendem Krankheitsverlauf vermehren, was sich ungünstig auf den Anbau auswirkt.[23] Schließlich dehnen sich die nekrotischen Regionen so aus, dass die Pflanze zu welken beginnt, auch wenn eine Kronenfäule zu keinem Zeitpunkt des Krankheitsverlaufs beobachtet wurde.[23] Obwohl es eine parasitische Beziehung zu sein scheint, produziert der Pilz ein Induktor-Proteion (AsES), welches einen systemischen Schutz gegen Anthraknose der Gartenerdbeere bietet, was eine symbiotische Beziehung zwischen dem Pilz und der Pflanze anzeigen würde.[7]
Cangzhu
Cangzhu (Atractylodes lancea) ist eine Heilpflanze, die in Zentral-China wächst. A. strictum wächst darin als pilzlicher Endophyt und interagiert mit Cangzhu unter trockenen Bedingungen und verschafft der Pflanze so eine mäßige Toleranz gegen die Trockenheit. Unter diesen mäßig trockenen Bedingungen verbessert A. strictum die Enzymaktivität bei löslichen Zuckern, Proteinen und Prolin sowie Antioxidantien im Blatt, welche den Grad der Zellmembran-Oxidation verringerte. Dies erhöht bei Cangzhu den Abscisinsäure-Spiegel und das Wurzel-zu-Spross-Verhältnis. Während A. strictum die Auswirkungen geringer bis mäßiger Trockenheit lindert, gibt es keine Auswirkungen bei ausreichender Wasserversorgung oder starker Trockenheit.[8]
Maulbeerbäume
Bei Maclura cochinchinensis wächst Acremonium strictum als endophytischer Pilz, der vorrangig die Blätter der Pflanze infiziert. In dieser Beziehung spielt A. strictum die Rolle, eine Schutzreaktion auf pflanzenfressende Insekten auszulösen.[9]
Natürliche Stoffwechselprodukte
Acremostrictin
Acremostrictin kann aus verschiedenen Stämmen von A. strictum isoliert werden. Es handelt sich um einen hochgradig oxidierten, tricyclischen Lacton-Metaboliten.[24] Diese Verbindung verleiht der Pflanze schwache antibakterielle Eigenschaften gegen Micrococcus luteus, Salmonella enterica subsp. enterica und Proteus vulgaris. Sie hat jedoch keine Auswirkungen auf Bacillus subtilis, Staphylococcus aureus und Escherichia coli.[24] Bei Acremostrictin wurde eine konzentrationsabhängige antioxidative Aktivität nachgewiesen, welche Schutz gegen durch oxidativen Stress induzierten Zelltod bietet. Außerdem wurde die Hemmung eines H2O2-induzierten Todes menschlicher keratinozytischer HaCaT-Zellen nachgewiesen. Wenn es extrahiert und durch Filtration isoliert wird, zeigt sich Acremostrictin als farbloser kristalliner Feststoff.[24]
AsES
Das Protein AsES (A. strictum Elicitor Subtilisin[25]) ist ein extrazellulärer Induktor, der von A. strictum produziert wird und einen vollständigen systemischen Schutz gegen Anthraknose bietet, die durch Pilzarten der Gattung Glomerella sowohl in der Gartenerdbeere als auch im „Unkraut“ Acker-Schmalwand (Arabidopsis thaliana) hervorgerufen wird. Anthraknose kann alle Gewebearten betreffen und erscheint als unregelmäßiger schwarzer Blattfleck, Blütenbleiche und Frucht- und Kronenfäule, was zu ernsthaften Verlusten bei Pflanzen- und Fruchtproduktion führt. AsES hat eine proteolytische Aktivität, die eine Immunantwort in diesen Arten zu induzieren scheint, die in einer Anreicherung von Sauerstoffradikalen und der Expression in die Abwehr einbezogener Gene wie PR1 (englisch Pathogenesis-related protein 1) und Chi2-1 zu enden scheint. Weil es auch in anderen als Kulturpflanzen einen systemischen Schutz bewirkt, könnte AsES in eine mögliche Strategie der Bekämpfung von Anthraknose bei Pflanzen einbezogen werden.[7]
Cephalosporine
A. strictum produziert einige Sorten von Cephalosporinen, einer Gruppe von Antibiotika.
Industrielle Nutzung
BMOs
Biogene Manganoxide (englisch Biogenic Mn oxides BMOs) sind natürlich vorkommende Manganoxide, welche die Fähigkeit haben, verschiedene Redox-sensitive Elemente zu oxidieren. A. strictum ist ein Mn(II)-oxidierender Pilz, der BMOs durch die Aktivität einer Mn(II)-Oxidase bildet. In Anwesenheit von BMOs in Pufferlösungen ohne zusätzliche Nährstoffe ist A. strictum fähig, über mindestens acht Tage hohe Konzentrationen von Mn(II) abzusondern, in denen die Menge gelösten Mangans(II) rasch innerhalb weniger Stunden steigt und zu oxidiertem Mn(II) umgewandelt wird. Eine Sauerstofffreimachung der Pufferlösung mit Stickstoff führt zu einer unterdrückten Mn(II)-Umwandlung; dies kann durch Belüftung rückgängig gemacht werden, woraus geschlossen werden kann, dass gelöster Sauerstoff für die Mn(II)-Absonderung und den Oxidationsprozess erforderlich ist. Durch Zugabe von Natriumazid, einer giftigen Substanz, wird die Absonderungsrate der pilzlichen BMOs gleichfalls gesenkt. Die Zugabe von Hitze zeigte unter 85 °C keine Änderung der Konformation der Mn(II)-Oxidase in den BMOs. Ein Einfrieren der pilzlichen BMOs bei −80 °C für vier Wochen beeinflusste nicht die Fähigkeit, Mn(II) abzusondern, und das reduzierbare Mangan dominierte weiterhin in der Lösung. Dies alles macht pilzliche BMOs wenn nötig zu effektiven Mn(II)-Quellen. Das kann zum Beispiel genutzt werden, um mit Mn(II) kontaminiertes Wasser ohne Zugabe irgendwelcher Additiva außer gelöstem Sauerstoff zu reinigen. Das Produkt ist eine oxidische Phase von Mn(II), die zusätzliche Affinität für andere giftige Elemente bieten und so zu einer effektiven Wasserreinigungsmethode entwickelt werden könnte. Enzymatisch aktive pilzliche BMOs können unter bestimmten Kultur-Bedingungen gewonnen werden und bleiben selbst unter für ein pilzliches Wachstum ungünstigen Bedingungen aktiv.[11]
Ginsenosid-Analoga
Die Fermentation des Ginsenosids Rb(1) durch A. strictum erzeugt drei neue Verbindungen:
- 12β-Hydroxydammar-3-one-20 (S)-O-β-D-Glucopyranosid,
- 12β, 25-Dihydroxydammar-(E)-20(22)-ene-3-O-β-D-Glucopyranosyl-(1→2)-β-D-Glucopyranosid und
- 12β, 20 (R), 25-Trihydroxydammar-3-O-β-D-Glucopyranosyl-(1→2)-β-D-Glucopyranosid.
Außerdem entstehen fünf bekannte Verbindungen:
- Ginsenosid Rd,
- Gypenosid XVII,
- Ginsenosid Rg,
- Ginsenosid F und
- Verbindung K.
Viele dieser Verbindungen sind Metabolite von Ginsenosid Rb(1) in Säugetieren, was nahelegt, dass die Fermentation von Ginsenosid Rb(1) in A. strictum ähnlich der in den Säugetieren ablaufen und ein nützliches Reagens für die Erzeugung spezieller Metabolite oder verwandter Ginsenosid-Analoga sein könnte, welche später für die strukturelle Aufklärung und die pharmazeutische Forschung genutzt werden könnten.[10]
Einzelnachweise
- ↑ a b c d e f g h J. Guarro, W. Gams, I. Puhhol, J. Gene: Acremonium species: new emerging fungal opportunists—in vitro antifungal susceptibilities and review. In: Clinical Infectious Diseases. Band 25, Nr. 5, 1997, S. 1222–1229, doi:10.1086/516098.
- ↑ a b c d e f W. A. Schell, J. R. Perfect: Fatal, disseminated Acremonium strictum infection in a neutropenic host. In: Journal of Clinical Microbiology. Band 34, Nr. 5, 1996, S. 1333–1336.
- ↑ a b c d e f g h i j k l m Ajanta Sharma, N. K. Hazarika, Purnima Barua, M. R. Shivaprakash, Arunalok Chakrabartie: Acremonium strictum: report of a rare emerging agent of cutaneous hyalohyphomycosis with review of literatures. In: Mycopathologia. Band 176, Nr. 5–6, 2013, S. 435–441, doi:10.1007/s11046-013-9709-1.
- ↑ a b c d e f R. M. Fincher, J. F. Fisher, R. D. Lovell, C. L. Newmann, A. Espinel-Ingroff, H. J. Shadomy: Infection due to the fungus Acremonium (cephalosporium). In: Medicine. Band 70, Nr. 6, 1991, S. 398–409, doi:10.1097/00005792-199111000-00005.
- ↑ a b c d e f g h i H. Perdomo, D. A. Sutton, D. Garcia, A. W. Fothergill, J. Cano, J. Gene. R. C. Summerbell, M. G. Rinaldi, J. Guarro: Spectrum of clinically relevant Acremonium species in the United States. In: Journal of Clinical Microbiology. Band 49, Nr. 1, 2010, S. 243–256, doi:10.1128/jcm.00793-10.
- ↑ a b c V. V. Rivera-Varas, T. A. Freeman, N. C. Gudmestad, G. A. Secor: Mycoparasitism of Helminthosporium solani by Acremonium strictum. In: Phytopathology. Band 97, Nr. 10, 2007, S. 1331–1337, doi:10.1094/phyto-97-10-1331.
- ↑ a b c d N. R. Chalfoun, C. F. Grellet-Bournonville, M. G. Martinez-Zamora, A. Diaz-Perales, A. P. Castagnaro, J. C. Diaz-Ricci: Purification and characterization of AsES protein: a subtilisin secreted by Acremonium strictum is a novel plant defense elicitor. In: Journal of Biological Chemistry. Band 288, Nr. 20, 2013, S. 14098–14113, doi:10.1074/jbc.m112.429423.
- ↑ a b T. Yang, S. Ma, C. C. Dai: Drought degree constrains the beneficial effects of a fungal endophyte on Atractylodes lancea. In: Journal of Applied Microbiology. Band 117, Nr. 5, 2014, S. 1435–1449, doi:10.1111/jam.12615.
- ↑ a b Sheng-Liang Zhou, Shu-Zhen Yan, Qi-Sha Liu, Shuang-Lin Chen: Diversity of endophytic fungi associated with the foliar tissue of a hemi-parasitic plant Macrosolen cochinchinensis. In: Current Microbiology. Band 70, Nr. 1, 2014, S. 58–66, doi:10.1007/s00284-014-0680-y.
- ↑ a b G. T. Chen, M. Yang, Y. Song, J. Q. Zhang, H. L. Huang, L. J. Wu, D. A. Guo: Microbial transformation of ginsenoside Rb1 by Acremonium strictum. In: Applied Microbiology and Biotechnology. Band 77, Nr. 6, 2008, S. 1345–1350, doi:10.1007/s00253-007-1258-4.
- ↑ a b Jianing Chang, Yukinori Tani, Hirotaka Naitou, Haruhiko Seyama: Fungal Mn oxides supporting Mn(II) oxidase activity as effective Mn(II) sequestering materials. In: Environmental Technology. Band 34, Nr. 19, 2013, S. 2781–2787, doi:10.1080/09593330.2013.790066.
- ↑ a b c d e f R. C. Summerbell, C. Gueidan, H.-J. Schroers, G. S. de Hoog, M. Starink, Y. Arocha Rosete, J. Guarro, J. A. James: Acremonium phylogenetic overview and revision of Gliomastix, Sarocladium, and Trichothecium. In: Studies in Mycology. Band 68, 2011, S. 139–162, doi:10.3114/sim.2011.68.06.
- ↑ a b J. F. Leslie: Sorghum and Millets Diseases. Hrsg.: John Wiley & Sons. 2008, ISBN 978-0-470-38470-1, S. 188–189.
- ↑ a b Jaideep Goswami, Rajesh Kumar Pandey, J. P. Tewari, B. K. Goswami: Management of root knot nematode of tomato through application of fungal antagonists, Acremonium strictum and Trichoderma harzianum. In: Journal of Environmental Science and Health. Band 43, Nr. 3, 2008, S. 237–240, doi:10.1080/03601230701771164.
- ↑ a b c C. K. Campbell, E. M. Johnson: Identification of Pathogenic Fungi. Hrsg.: John Wiley & Sons. 2013, ISBN 978-1-118-52004-8, S. 178–179.
- ↑ a b T. J. Novicki, K. LaFe, L. Bui, R. Geise, K. Marr, B. T. Cookson: Genetic diversity among clinical isolates of Acremonium strictum determined during an investigation of a fatal mycosis. In: Journal of Clinical Microbiology. Band 41, Nr. 6, 2003, S. 2623–2328, doi:10.1128/jcm.41.6.2623-2628.2003.
- ↑ a b J. Guarro, A. Del Palacio, J. Cano, C. G. Gonzalez: A case of colonization of a prosthetic mitrial valve by Acremonium strictum. In: Revista Iberoamericana de Micología. Band 26, Nr. 2, 2009, S. 146–148, doi:10.1016/s1130-1406(09)70025-7.
- ↑ a b c d e f g h Species Fungorum. In: Index Fungorum. Abgerufen am 3. September 2019.
- ↑ a b Acremonium strictum. In: MycoBank. Abgerufen am 3. September 2019.
- ↑ a b c A. G. Sener, M. Yucesoy, Seckin Senturkun, Ilhan Afsar, S. G. Yurtsever, M. Turk: A case of Acremonium strictum peritonitis. In: Med. Mycol. Band 46, Nr. 5, 2008, S. 495–497, doi:10.1080/13693780701851729.
- ↑ a b A. Koc, M. Sariguzel, T. Artis: Pleuritis caused by Acremonium strictum in a patient with colon adenocarcinoma. In: Mycoses. Band 51, Nr. 6, 2008, S. 554–556, doi:10.1111/j.1439-0507.2008.01517.x.
- ↑ P. E. Zida, P. Sereme, V. Leth, P. Sankara, I. Somda, A. Neva: Importance of seed-borne fungi of sorghum and pearl millet in Burkina Faso and their control using plant extracts. In: Pakistan Journal of Biological Sciences. Band 11, Nr. 3, 2008, S. 321–331, doi:10.3923/pjbs.2008.321.331.
- ↑ a b J. Racedo, S. M. Salazar, P. Castagnaro, J. C. Diaz Ricci: A strawberry disease caused by Acremonium strictum. In: European Journal of Plant Pathology. Band 137, Nr. 4, 2013, S. 649–654, doi:10.1007/s10658-013-0279-3.
- ↑ a b c Elin Julianti, Hana Oh, Kyoung Hwa Jang, Jae Kyun Lee, Sang Kook Lee, Dong-Chang Oh, Ki-Bong Oh, Jongheon Shin: Acremostrictin, a highly oxygenated metabolite from the marine fungus Acremonium strictum. In: Journal of Natural Products. Band 74, Nr. 12, 2011, S. 2592–2594, doi:10.1021/np200707y.
- ↑ UniProt: UniProtKB - R4IR27 (ASES_SARSR) R4IR27, abgerufen am 13. September 2019